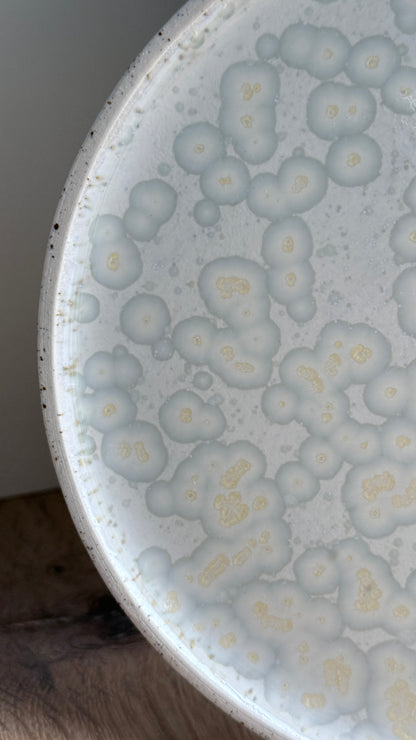
Dessert / Sushi plate, dots w/ crystal glaze

Mia Maya Design
Dessert / Sushi plate, dots w/ crystal glaze
Dessert / Sushi plate, dots w/ crystal glaze
Couldn't load pickup availability
Dessert / kage / sushi tallerken
Denne lille tallerken er velegnet til dessert, forret, kage, sushi eller andre småretter. Tallerkenen er lavet i stentøjsler med grå jern-prikker. Efter den første brænding er tallerkenen glaseret på indersiden med krystalglasur og efterfølgende vandslebet på ydersiden.
Ø: 17 cm.
H: 1 cm.
Der er variationer i alle produkter, da de er fremstillet i hånden. Hvert enkelt produkt er støbt, pudset, glaseret, dekoreret og efterfølgende vandslebet i hånden. Produkterne er designet og fremstillet på værkstedet i København og alle dele kan komme i opvaskemaskinen og i microbølgeovnen.
Lunch Plate Stoneware / Stone Blue
The plate is carefully slip casted in stoneware with grey iron specks. After the first firing it is glazed on the inside with a crystal glaze and then sand washed on the outside, which makes it smooth and soft to the touch..
Artisanal products may vary slightly as they are hand made. Each product is carefully slip casted, polished, glazed, decorated and ultimately sand washed by hand. The products are designed and produced in our workshop in Copenhagen, and all parts are dishwasher and microwave friendly.
Share